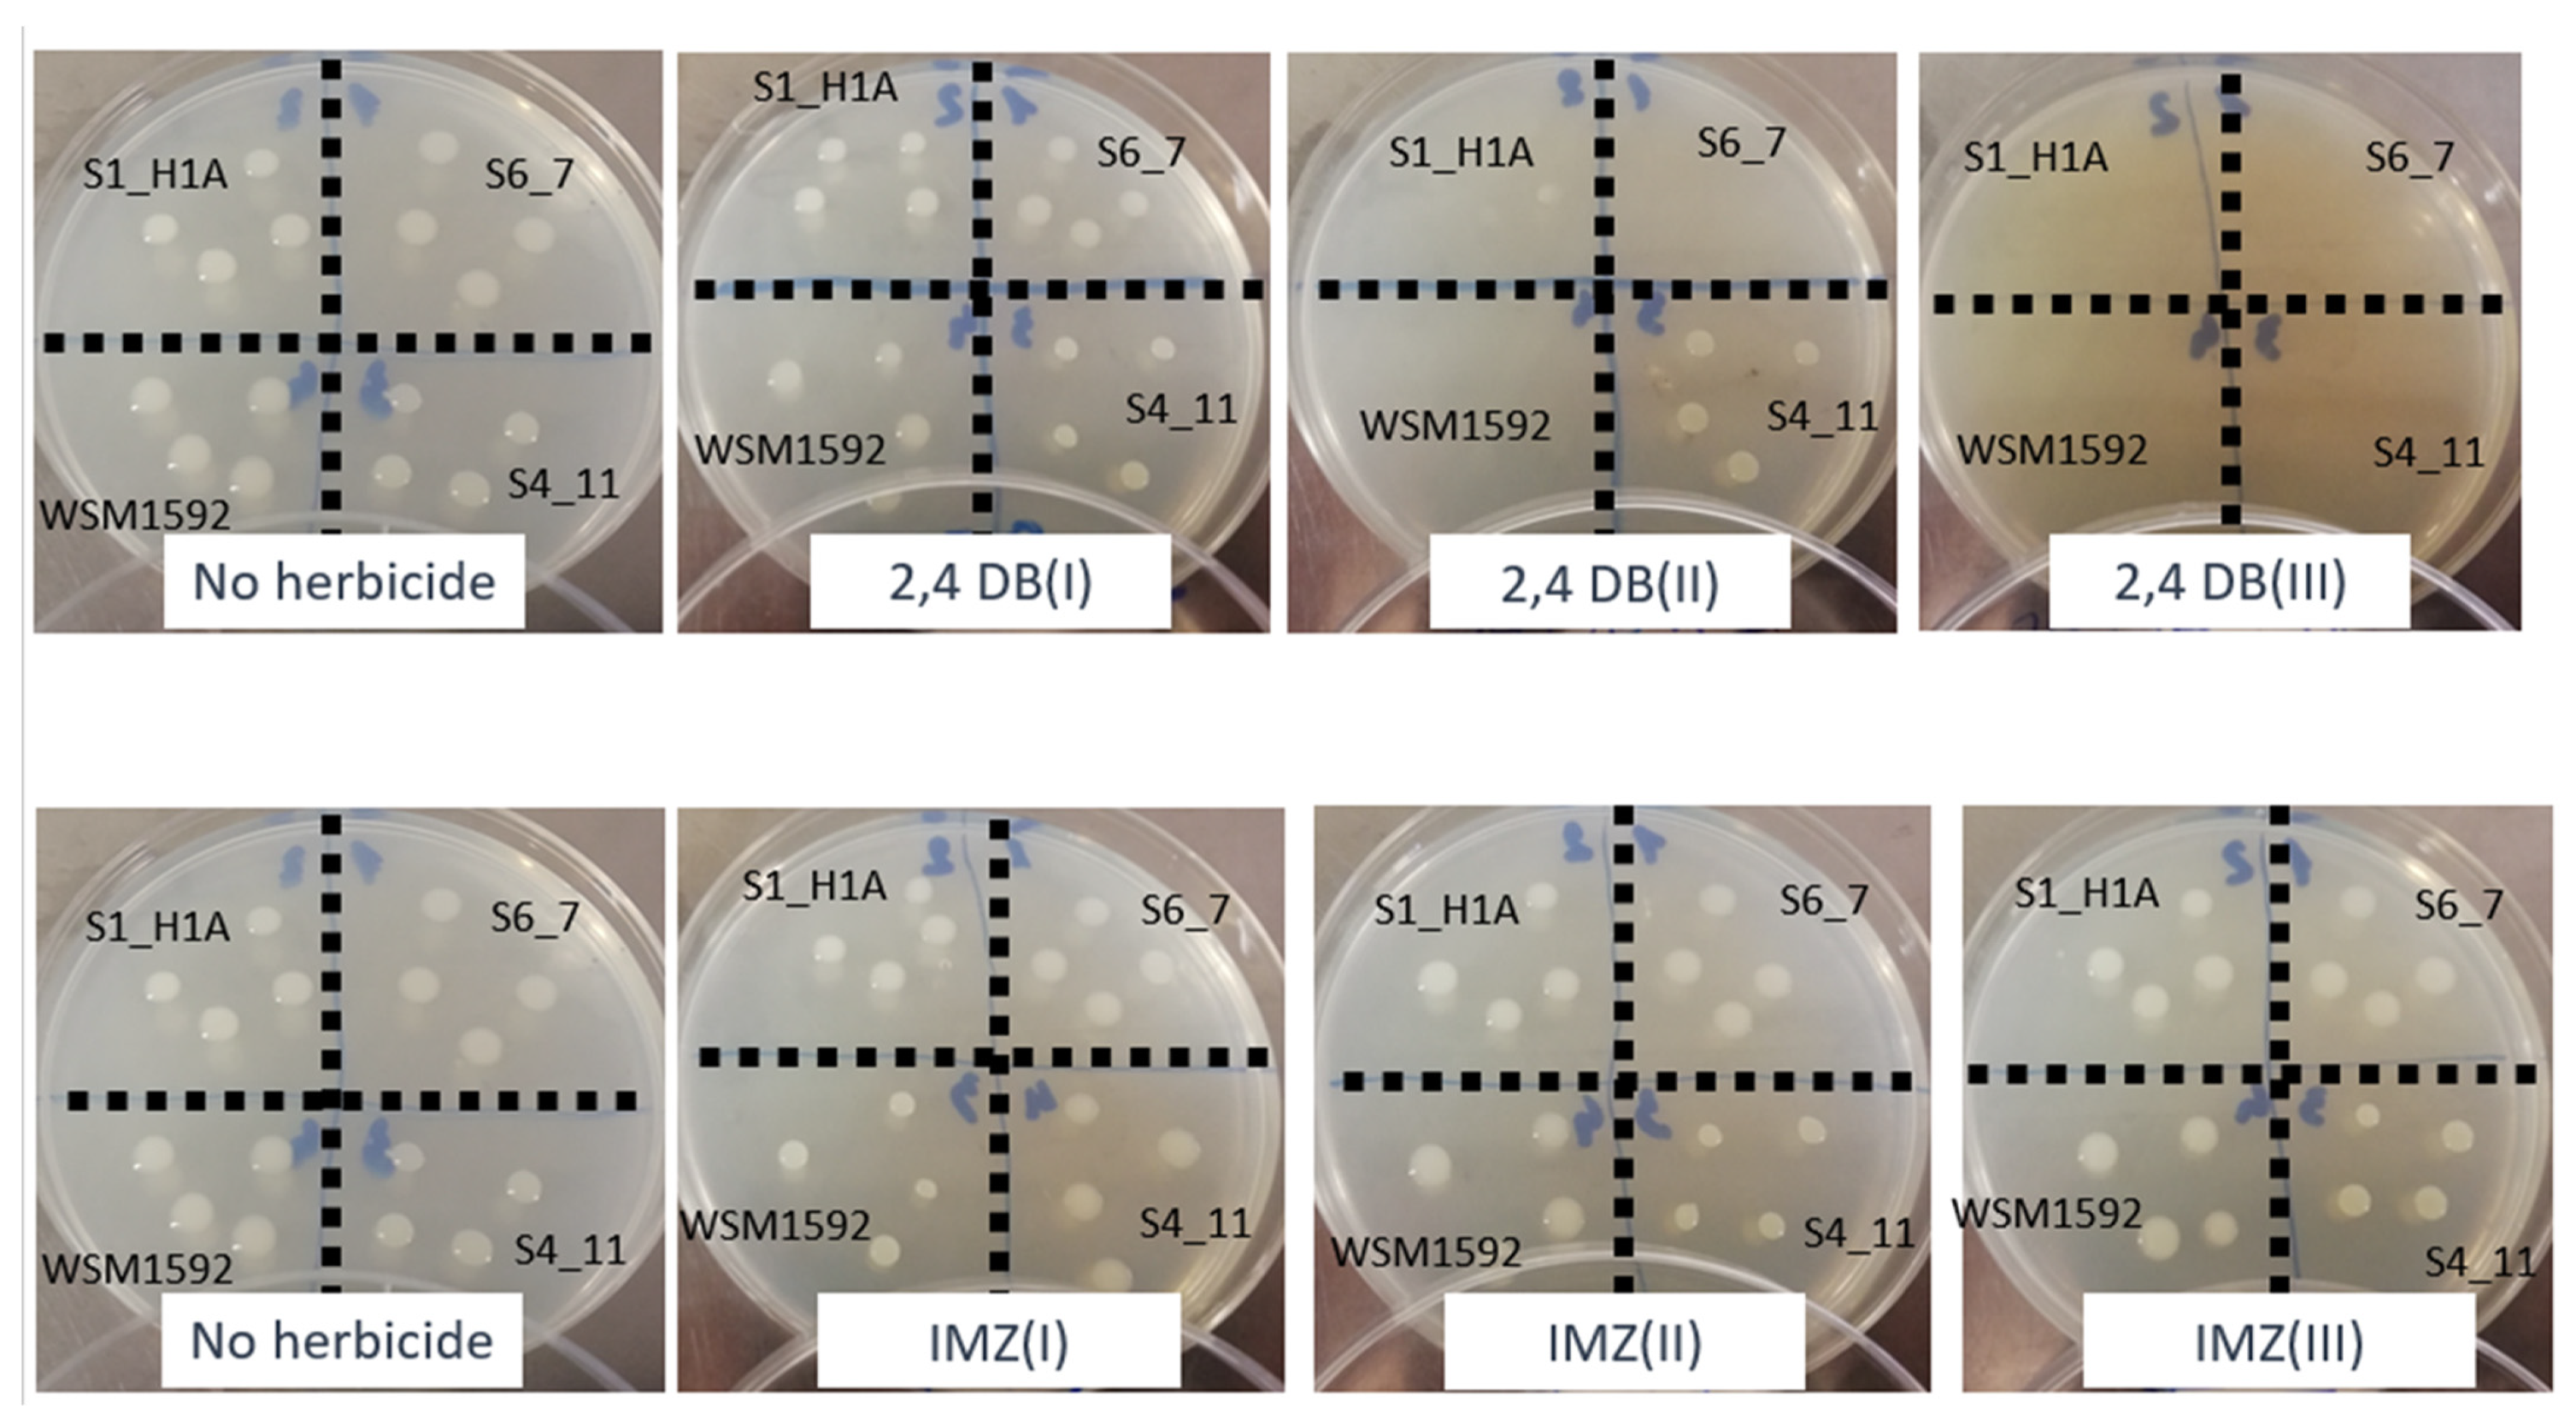
Agriculture 12 01862 g006 Agriculture 12 01862 g006

Sorption–Desorption of Imazamox and 2,4-DB in Acidic Mediterranean Agricultural Soils and Herbicide Impact on Culturable Bacterial Populations and Functional Diversity
Abstract
1. Introduction
2. Materials and Methods
2.1. Origin of Soils and Physicochemical Analyses
2.2. Sorption–Desorption Experiments
2.3. HPLC Analyses
2.4. Processing of Sorption–Desorption Data
2.5. Microcosm Set-Up
2.6. Culturable Microorganisms
2.7. Community-Level Physiological Profile
2.8. Soil Basal Respiration
2.9. Soil Enzyme Activities
2.10. Growth Inhibition of R. sullae
2.11. Statistical Analysis of Data
3. Results and Discussion
3.1. Herbicide Sorption–Desorption
3.2. Influence of DB and IMZ on Selected Soil Culturable Bacterial Populations and Total Bacteria
3.3. Influence of DB and IMZ on Soil Respiration and Enzyme Activity
3.4. Influence of DB and IMZ on the Biolog Community-Level Physiological Profile
3.5. Influence of DB and IMZ on R. sullae Growth
4. Conclusions
Supplementary Materials
Author Contributions
Funding
Institutional Review Board Statement
Data Availability Statement
Conflicts of Interest
References
- Riah, W.; Laval, K.; Laroche-Ajzenberg, E.; Mougin, C.; Latour, X.; Trinsoutrot-Gattin, I. Effects of pesticides on soil enzymes: A review. Environ. Chem. Lett. 2014, 12, 257–273. [Google Scholar] [CrossRef]
- Lupwayi, N.Z.; Harker, K.N.; Clayton, G.W.; Turkington, T.K.; Rice, W.A.; O’Donovan, J.T. Soil microbial biomass and diversity after herbicide application. Can. J. Plant Sci. 2004, 84, 677–685. [Google Scholar] [CrossRef]
- Del Pilar Castillo, M.; Torstensson, L.; Stenström, J. Biobeds for environmental protection from pesticide use-A Review. J. Agr. Food Chem. 2008, 56, 6206–6219. [Google Scholar] [CrossRef] [PubMed]
- European Food Safety Authority (EFSA). Scientific opinion on the development of specific protection goal options for environmental risk assessment of pesticides, in particular in relation to the revision of the guidance documents on aquatic and terrestrial ecotoxicology. EFSA J. 2010, 8, 1821–1876. [Google Scholar] [CrossRef]
- Nannipieri, P.; Kandeler, E.; Ruggiero, P. Enzyme activities and microbiological and biochemical processes in soil. In Enzymes in the Environment: Activity, Ecology and Applications; Burns, R.G., Dick, R.P., Eds.; Marcel Dekker Inc.: New York, NY, USA, 2002; Chapter 1; pp. 1–33. [Google Scholar]
- Araujo, A.S.F.; Monteiro, R.T.R.; Abarkeli, R.B. Effect of glyphosate on the microbial activity of two Brazilian soils. Chemosphere 2003, 52, 799–804. [Google Scholar] [CrossRef]
- Diquattro, S.; Garau, G.; Mangia, N.P.; Drigo, B.; Lombi, E.; Vasileiadis, S.; Castaldi, P. Mobility and potential bioavailability of antimony in contaminated soils: Short-term impact on microbial community and soil biochemical functioning. Ecotox. Environ. Saf. 2020, 196, 110576. [Google Scholar] [CrossRef]
- Sherp, A.M.; Lee, S.G.; Schraft, E.; Jez, J.M. Modification of auxinic phenoxyalkanoic acid herbicides by the acyl acid amido synthetase GH3. 15 from Arabidopsis. J. Biol. Chem. 2018, 293, 17731–17738. [Google Scholar] [CrossRef]
- Tomlin, C. The Pesticide Manual: A World Compendium, 14th ed.; British Crop Protection Council: Alton, UK, 2006. [Google Scholar]
- Rojano-Delgado, A.M.; Priego-Capote, F.; Luque de Castro, M.D.; De Prado, R. Mechanism of imazamox resistance of the Clearfield® wheat cultivar for better weed control. Agron. Sustain. Dev. 2015, 35, 639–648. [Google Scholar] [CrossRef]
- Zabaloy, M.C.; Garland, J.L.; Gomez, M.A. Assessment of the impact of 2,4-dichlorophenoxyacetic acid (2,4-D) on indigenous herbicide-degrading bacteria and microbial community function in an agricultural soil. Appl. Soil Ecol. 2010, 46, 240–246. [Google Scholar] [CrossRef]
- Smejkal, C.W.; Seymour, F.A.; Burton, S.K.; Lappin-Scott, H.M. Characterization of bacterial cultures enriched on the chlorophenoxyalkanoic acid herbicides 4-(2,4-dichlorophenoxy) butyric acid and 4-(4-chloro-2-methylphenoxy)butyric acid. J. Ind. Microbiol. Biotechnol. 2003, 30, 561–567. [Google Scholar] [CrossRef]
- Sim, J.X.F.; Doolette, C.L.; Vasileiadis, S.; Drigo, B.; Wyrsch, E.R.; Djordjevic, S.P.; Donner, E.; Karpouzas, D.G.; Lombi, E. Pesticide effects on nitrogen cycle related microbial functions and community composition. Sci. Total Environ. 2022, 807, 150734. [Google Scholar] [CrossRef] [PubMed]
- Fabra, A.; Permigiani, M.; Castro, S. Effects of the herbicides 2,4-DB, Pivot and Scepter on two species of Rhizobium. Phyton 1997, 60, 93–98. [Google Scholar]
- Santos, J.B.; Silva, A.A.; Costa, M.D.; Jakelaitis, A.; Vivian, R.; Santos, E.A. Herbicide action on the growth of Rhizobium tropici strains. Planta Daninha 2006, 24, 457–465. [Google Scholar] [CrossRef]
- Yates, R.; Howieson, J.; De Meyer, S.E.; Tian, R.; Seshadri, R.; Pati, A.; Woyke, T.; Markowitz, V.; Ivanova, N.; Kyrpides, N.; et al. High-quality permanent draft genome sequence of Rhizobium sullae strain WSM1592; a Hedysarum coronarium microsymbiont from Sassari, Italy. Stand Genom. Sci. 2015, 10, 44. [Google Scholar] [CrossRef]
- Navarro, S.; Vela, N.; Navarro, G. An overview on the environmental behaviour of pesticide residues in soils. J. Agric. Res. 2007, 5, 357–375. [Google Scholar] [CrossRef]
- Pinna, M.V.; Pusino, A. Influence of the isomerism on the sorption of imazamethabenz-methyl by soil. Chemosphere 2013, 91, 265–268. [Google Scholar] [CrossRef]
- Chessa, L.; Pusino, A.; Garau, G.; Mangia, N.P.; Pinna, M.V. Soil microbial response to tetracycline in two different soils amended with cow manure. Environ. Sci. Pollut. Res. 2016, 23, 5807–5817. [Google Scholar] [CrossRef]
- Kchour, H.; Pinna, M.V.; Nassif, N.; Pusino, A. Impact of biochar on herbicide pollution in the Litani river Basin. Fres. Environ. Bull. 2020, 29, 11119–11128. [Google Scholar]
- Pinna, M.V.; Castaldi, P.; Deiana, P.; Pusino, A.; Garau, G. Sorption behavior of sulfamethazine on unamended and manure-amended soils and short-term impact on soil microbial community. Ecotoxicol. Environ. Saf. 2012, 84, 234–242. [Google Scholar] [CrossRef]
- Oliveira, R.S.J.; Koskinen, W.C.; Ferreira, F.A.; Khakural, B.R.; Mulla, D.J.; Robert, P.C. Spatial variability of sorption/desorption of imazethapyr. Weed Sci. 1999, 47, 243–248. [Google Scholar] [CrossRef]
- Werner, D.; Garratt, J.A.; Pigott, G. Sorption of 2,4-D and other phenoxy herbicides to soil, organic matter, and minerals. J. Soil Sed. 2013, 13, 129–139. [Google Scholar] [CrossRef]
- Bian, M.; Zhou, M.; Sun, D.; Li, C. Molecular approaches unravel the mechanism of acid soil tolerance in plants. Crop J. 2013, 1, 91–104. [Google Scholar] [CrossRef]
- Tan, K.M. Soil Sampling. Preparation and Analysis; Routledge: Boca Raton, FL, USA, 1996. [Google Scholar]
- Official Gazette of the Italian Republic. Official Methods for Chemical Analysis of Soils; Official Gazette of the Italian Republic: Rome, Italy, 1992. [Google Scholar]
- Pinna, M.V.; Roggero, P.P.; Seddaiu, G.; Pusino, A. Soil sorption and leaching of active ingredients of Lumax® under mineral or organic fertilization. Chemosphere 2014, 111, 372–378. [Google Scholar] [CrossRef] [PubMed]
- Chen, Z.; Xing, B.; McGill, W.B. A unified sorption variable for environmental applications of the Freundlich equation. J. Environ. Qual. 1999, 28, 1422–1428. [Google Scholar] [CrossRef]
- Góngora-Echeverría, V.R.; Martin-Laurent, F.; Quintal-Franco, C.; Flores, A.L.; Giácoman-Vallejos, G.; Ponce-Caballero, C. Dissipation and adsorption of 2,4-D, atrazine, diazinon, and glyphosate in an agricultural soil from Yucatan State, Mexico. Water Air Soil Pollut. 2019, 230, 131. [Google Scholar] [CrossRef]
- Zabaloy, M.C.; Garland, J.L.; Gómez, M.A. An integrated approach to evaluate the impacts of the herbicides glyphosate, 2,4-D and metsulfuron-methyl on soil microbial communities in the Pampas region, Argentina. Appl. Soil Ecol. 2008, 40, 1–12. [Google Scholar] [CrossRef]
- Islam, F.; Wang, J.; Farooq, M.A.; Khan, M.S.S.; Xu, L.; Zhu, J.; Zhao, M.; Muños, S.; Li, Q.X.; Zhou, W. Potential impact of the herbicide 2,4-dichlorophenoxyacetic acid on human and ecosystems. Environ. Int. 2018, 111, 332–351. [Google Scholar] [CrossRef]
- Garau, G.; Morillas, L.; Roales, J.; Castaldi, P.; Mangia, N.P.; Spano, D.; Mereu, S. Effect of monospecific and mixed Mediterranean tree plantations on soil microbial community and biochemical functioning. Appl. Soil Ecol. 2019, 140, 78–88. [Google Scholar] [CrossRef]
- Garland, J.L. Analysis and interpretation of community-level physiological profiles in microbial ecology. FEMS Microbiol. Ecol. 1997, 24, 289–300. [Google Scholar] [CrossRef]
- Marabottini, R.; Stazi, S.R.; Papp, R.; Grego, S.; Moscatelli, M.C. Mobility and distribution of arsenic in contaminated mine soils and its effects on the microbial pool. Ecotoxicol. Environ. Saf. 2013, 96, 147–153. [Google Scholar] [CrossRef]
- Alef, K.; Nannipieri, P. Methods in Applied Soil Microbiology and Biochemistry; Academic Press: London, UK, 1995. [Google Scholar]
- Somasegaran, P.; Hoben., H.J. Handbook for Rhizobia. Methods in Legume-Rhizobium Technology; Springer: New York, NY, USA, 1994; p. 450. [Google Scholar]
- Pintado, S.; Ruiz Montoya, M.; Rodriguez Mellado, J.M. Imidazolinone herbicides in strongly acidic media: Speciation and electroreduction. Comptes Rendus. Chim. 2011, 14, 957–962. [Google Scholar] [CrossRef]
- Giles, C.H.; MacEwan, T.H.; Nakhwa, S.N.; Smith, D. Studies in adsorption: Part XI. A system of classification of solution adsorption isotherms, and its use in diagnosis of adsorption mechanisms and in measurement of specific surface areas of solids. J. Chem. Soc. 1960, 111, 3973–3993. [Google Scholar] [CrossRef]
- Sposito, G. Inorganic and organic solute adsorption in soil. In The Surface Chemistry of Soils; Oxford University Press: Oxford, UK, 1984; Chapter 4; pp. 113–153. [Google Scholar]
- Aichele, T.M.; Penner, D. Adsorption, desorption, and degradation of Imidazolinones in soil. Weed Technol. 2005, 19, 154–159. [Google Scholar] [CrossRef]
- Hiller, E.; Tatarkova, V.; Simonovicova, A.; Bartal, M. Sorption, desorption, and degradation of (4-chloro-2-methylphenoxy) acetic acid in representative soils of the Danubian lowland, Slovakia. Chemosphere 2012, 87, 437–444. [Google Scholar] [CrossRef]
- Olsen, R.A.; Bakken, L.R. Viability of soil bacteria: Optimization of plate-counting technique and comparison between total counts and plate counts within different size groups. Microb. Ecol. 1987, 13, 59–74. [Google Scholar] [CrossRef]
- Cuadrado, V.; Merini, L.J.; Flocco, C.G.; Giulietti, A.M. Degradation of 2,4-DB in Argentinean agricultural soils with high humic matter content. Appl. Microbiol. Biotechnol. 2008, 77, 1371–1378. [Google Scholar] [CrossRef]
- Zhang, C.; Liu, X.; Dong, F.; Xu, J.; Zheng, Y.; Li, J. Soil microbial communities response to herbicide 2,4-dichlorophenoxyacetic acid butyl ester. Eur. J. Soil Biol. 2010, 46, 175–180. [Google Scholar] [CrossRef]
- Park, I.; Ka, J. Isolation and characterization of 4-(2,4-Dichlorophenoxy)Butyric Acid-degrading bacteria from agricultural soils. J. Microbiol. Biotechnol. 2003, 13, 243–250. [Google Scholar]
- Cuadrado, V.; Gomila, M.; Merini, L.; Giulietti, A.M.; Moore, E.R.B. Cupriavidus pampae sp. nov., a novel herbicide-degrading bacterium isolated from agricultural soil. Int. J. Syst. Evol. Microbiol. 2010, 60, 2606–2612. [Google Scholar] [CrossRef]
- Vasic, V.; Djuric, S.; Jafari-Hajnal, T.; Orlovic, S.; Vasic, S.; Poljakovic Pajnik, L.; Galović, V. The microbiological response of forest soils after application of nicosulfuron, imazamox and cycloxydim. Int. J. Environ. Sci. Technol. 2019, 16, 2305–2312. [Google Scholar] [CrossRef]
- Huang, X.; Pan, J.; Liang, B.; Sun, J.; Zhao, Y.; Li, S. Isolation, characterization of a strain capable of degrading imazethapyr and its use in degradation of the herbicide in soil. Curr. Microbiol. 2009, 59, 363–367. [Google Scholar] [CrossRef] [PubMed]
- Kaur, P.; Kaur, P.; Kaur, N.; Jain, D.; Singh, K.; Bhullar, M.S. Dissipation and phytotoxicity of imazethapyr and imazamox in soils amended with β-cyclodextrin-chitosan biocomposite. Sci. Total Environ. 2020, 735, 139566. [Google Scholar] [CrossRef] [PubMed]
- Blagodatskaya, E.; Kuzyakov, Y. Active microorganisms in soil: Critical review of estimation criteria and approaches. Soil Biol. Biochem. 2013, 67, 192–211. [Google Scholar] [CrossRef]
- Yang, X.; Yuan, J.; Li, N.; Franks, A.E.; Shentu, J.; Luo, Y.; Xu, J.; He, Y. Loss of microbial diversity does not decrease γ-HCH degradation but increases methanogenesis in flooded paddy soil. Soil Biol. Biochem. 2021, 156, 108210. [Google Scholar] [CrossRef]
- Xu, M.; Li, X.; Kuyper, T.W.; Xu, M.; Li, X.; Zhang, J. High microbial diversity stabilizes the responses of soil organic carbon decomposition to warming in the subsoil on the Tibetan Plateau. Glob. Chang. Biol. 2021, 27, 2061–2075. [Google Scholar] [CrossRef] [PubMed]
- Sagliker, H.A.; Ozdal, N.K. How do Imazamox additions affect carbon and nitrogen mineralization in sunflower soil? Water Air Soil Pollut. 2021, 232, 514. [Google Scholar] [CrossRef]
- Tomar, U.; Baishya, R. Seasonality and moisture regime control soil respiration, enzyme activities, and soil microbial biomass carbon in a semi-arid forest of Delhi, India. Ecol. Proc. 2020, 9, 50. [Google Scholar] [CrossRef]
- Kaur, L.; Kaur, P. Degradation of imazethapyr in soil: Impact of application rate, soil physicochemical properties and temperature. Int. J. Environ. Sci. Technol. 2022, 19, 1877–1892. [Google Scholar] [CrossRef]
- Wolinska, A.; Stępniewska, Z. Dehydrogenase activity in the soil environment. In Dehydrogenases; Canuto, R.A., Ed.; Intech: Rijeka, Croatia, 2012; pp. 183–209. [Google Scholar]
- Friedel, J.K.; Molter, K.; Fischer, W.R. Comparison and improvement of methods for determining soil dehydrogenase activity by using triphenyltetrazolium chloride and iodonitro- tetrazolium chloride. Biol. Fert. Soils 1994, 18, 291–296. [Google Scholar] [CrossRef]
- Januszek, K.; Błońska, E.; Długa, J.; Socha, J. Dehydrogenase activity of forest soils depends on the assay used. Int. Agrophys. 2015, 29, 47–59. [Google Scholar] [CrossRef]
- Chang, Y.C.; Reddy, M.V.; Umemoto, H.; Sato, Y.; Kang, M.H.; Yajima, Y.; Kikuchi, S. Bio-augmentation of Cupriavidus sp. CY-1 into 2, 4-D contaminated soil: Microbial community analysis by culture dependent and independent techniques. PLoS ONE 2015, 10, e0145057. [Google Scholar] [CrossRef] [PubMed][Green Version]
- Saha, S.; Dutta, D.; Karmakar, R.; Prasad Ray, D. Structure–toxicity relationship of chloroacetanilide herbicides: Relative impact on soil microorganisms. Environ. Toxicol. Pharmacol. 2012, 34, 307–314. [Google Scholar] [CrossRef] [PubMed]
- Baćmaga, M.; Kucharski, J.; Wyszkowska, J.; Borowika, A.; Tomkiel, M. Response of microorganisms and enzymes to soil contamination with metazachlor. Environ. Earth Sci. 2014, 72, 2251–2262. [Google Scholar] [CrossRef]
- Bécaert, V.; Samson, R.; Deschênes, L. Effect of 2,4-D contamination on soil functional stability evaluated using the relative soil stability index (RSSI). Chemosphere 2006, 64, 1713–1721. [Google Scholar] [CrossRef] [PubMed]
- Douterelo, I.; Goulder, R.; Lillie, M. Soil microbial community response to land-management and depth, related to the degradation of organic matter in English wetlands: Implications for the in situ preservation of archaeological remains. Appl. Soil Ecol. 2010, 44, 219–227. [Google Scholar] [CrossRef]
- Garland, J.L. Analytical approaches to the characterization of samples of microbial communities using patterns of potential C source utilization. Soil Biol. Biochem. 1996, 28, 213–221. [Google Scholar] [CrossRef]
- Loranger–Merciris, G.; Barthes, L.; Gastine, A.; Leadley, P. Rapid effects of plant species diversity and identity on soil microbial communities in experimental grassland ecosystems. Soil Biol. Biochem. 2006, 38, 2336–2343. [Google Scholar] [CrossRef]
- Janniche, G.S.; Spliid, H.; Albrechtsen, H.J. Microbial Community-Level Physiological Profiles (CLPP) and herbicide mineralization potential in groundwater affected by agricultural land use. J. Cont. Hydrol. 2012, 140, 45–55. [Google Scholar] [CrossRef]
- Zaidi, A.; Khan, M.S.; Rizvi, P.Q. Effect of herbicides on growth, nodulation and nitrogen content of greengram. Agr. Sust. Dev. 2005, 25, 497–504. [Google Scholar] [CrossRef]
- García-Garijo, A.; Tejera, N.A.; Lluch, C.; Palma, F. Metabolic responses in root nodules of Phaseolus vulgaris and Vicia sativa exposed to the imazamox herbicide. Pest. Biochem. Phys. 2014, 111, 19–23. [Google Scholar] [CrossRef]
- Royuela, M.; Gonzalez, A.; Gonzalez, E.M.; Arrese-Igor, C.; Aparicio-Tejo, P.M.; Gonzalez-Murua, C. Physiological consequences of continuous, sublethal imazethapyr supply to pea plants. J. Plant Physiol. 2000, 157, 345–354. [Google Scholar] [CrossRef]
- Joux, F.; Lebaron, P. Use of fluorescent probes to assess physiological functions of bacteria at single-cell level. Microbes Infect. 2000, 2, 1523–1535. [Google Scholar] [CrossRef]

| Chemical Structure | pKa | Water Solubility (g L−1) | Log Kow | Recommended Application Rate | Mode of Action | |
|---|---|---|---|---|---|---|
| IMZ | ![]() | 2.3;3.3;10.8 | 4.16 | 0.73 | 40 g ha−1 | Acetolactate synthase inhibitor [10] |
| DB | ![]() | 4.95 | 46·10−3 | 3.53 | 1400 g ha−1 | Auxin mimic after conversion to 2,4-D [8] |
| Chemical Analyses | Soil A | Soil F |
|---|---|---|
| pH | 5.95 ± 0.03 | 6.40 ± 0.01 |
| EC (μS cm−1) | 480 ± 5 | 299 ± 1 |
| Cation exchange capacity (CEC, cmol(+) kg−1) | 16 ± 0.3 | 19 ± 0.2 |
| Total organic matter (OM, %) | 2.54 ± 0.03 | 2.19 ± 0.05 |
| Total nitrogen (g kg−1) | 1.35 ± 0.08 | 0.57 ± 0.05 |
| C/N | 11 ± 0.5 | 22 ± 1.8 |
| Extractable P (mg kg−1) | 1.6 ± 0.5 | 3.3 ± 0.6 |
| Exchangeable K (mg kg−1) | 96.29 ± 1.55 | 145.53 ± 1.85 |
| USDA textural classification | Silt loam | Sandy loam |
| Soil | Herbicide | Kads a | 1/nads | R2 | Kdes a | 1/ndes | R2 | H b |
|---|---|---|---|---|---|---|---|---|
| A | IMZ | 0.18 (±0.04) | 1.11 (±0.05) | 0.956 | 0.57 (±0.06) | 0.86 (±0.02) | 0.996 | 0.77 |
| F | 0.22 (±0.03) | 0.79 (±0.01) | 0.962 | 0.22 (±0.05) | 1.07 (±0.05) | 0.968 | 1.35 | |
| A | DB | 19.30 (±0.94) | 0.54 (±0.02) | 0.974 | 8.49 (±0.16) | 0.30 (±0.03) | 0.980 | 0.55 |
| F | 7.62 (±0.11) | 0.72 (±0.03) | 0.962 | 1.89 (±0.18) | 0.40 (±0.04) | 0.978 | 0.56 |
Publisher’s Note: MDPI stays neutral with regard to jurisdictional claims in published maps and institutional affiliations. |
© 2022 by the authors. Licensee MDPI, Basel, Switzerland. This article is an open access article distributed under the terms and conditions of the Creative Commons Attribution (CC BY) license (https://creativecommons.org/licenses/by/4.0/).
Share and Cite
Pinna, M.V.; Castaldi, P.; Garau, M.; Bianco, A.; Multineddu, C.; Cesarani, A.; Sitzia, M.; Diquattro, S.; Mangia, N.P.; Garau, G. Sorption–Desorption of Imazamox and 2,4-DB in Acidic Mediterranean Agricultural Soils and Herbicide Impact on Culturable Bacterial Populations and Functional Diversity. Agriculture 2022, 12, 1862. https://doi.org/10.3390/agriculture12111862
Pinna MV, Castaldi P, Garau M, Bianco A, Multineddu C, Cesarani A, Sitzia M, Diquattro S, Mangia NP, Garau G. Sorption–Desorption of Imazamox and 2,4-DB in Acidic Mediterranean Agricultural Soils and Herbicide Impact on Culturable Bacterial Populations and Functional Diversity. Agriculture. 2022; 12(11):1862. https://doi.org/10.3390/agriculture12111862
Chicago/Turabian StylePinna, Maria V., Paola Castaldi, Matteo Garau, Angela Bianco, Chiara Multineddu, Alberto Cesarani, Maria Sitzia, Stefania Diquattro, Nicoletta P. Mangia, and Giovanni Garau. 2022. "Sorption–Desorption of Imazamox and 2,4-DB in Acidic Mediterranean Agricultural Soils and Herbicide Impact on Culturable Bacterial Populations and Functional Diversity" Agriculture 12, no. 11: 1862. https://doi.org/10.3390/agriculture12111862
APA StylePinna, M. V., Castaldi, P., Garau, M., Bianco, A., Multineddu, C., Cesarani, A., Sitzia, M., Diquattro, S., Mangia, N. P., & Garau, G. (2022). Sorption–Desorption of Imazamox and 2,4-DB in Acidic Mediterranean Agricultural Soils and Herbicide Impact on Culturable Bacterial Populations and Functional Diversity. Agriculture, 12(11), 1862. https://doi.org/10.3390/agriculture12111862



